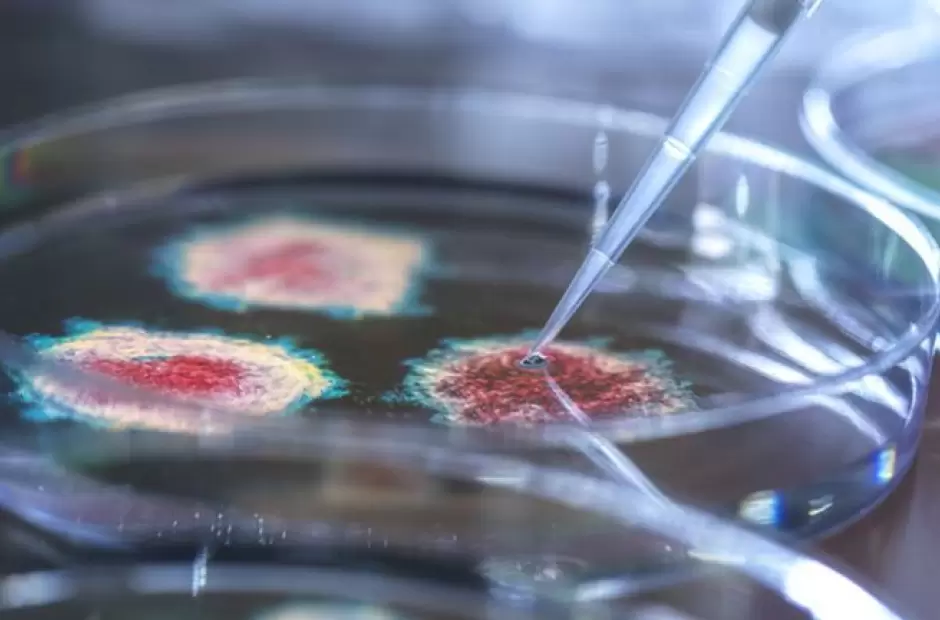

La Agencia de Seguridad Sanitaria del Reino Unido (UKHSA, por sus siglas en inglés), publicó un nuevo informe de vigilancia de las vacunas contra la Covid-19 en el que expuso los resultados obtenidos al aplicar dosis de refuerzos para proteger ante los contagios y hospitalizaciones por la nueva variante ómicron.
En el documento de 59 páginas expone los resultados obtenidos luego de aplicar una dosis de refuerzo con vacunas de ARN mensajero (Pfizer y Moderna) a sus habitantes que previamente habían recibido dos dosis de Pfizer, Moderna o AstraZeneca. El resultado obtenido demostró que el booster (refuerzo) resulta clave a partir de los cuatro meses de haber completado el esquema inicial.
Incluso, las autoridades del UKHSA identificaron que las personas que llevaban seis meses o más de haber completado el esquema inicial solo tenían una protección cercana o menor al 10% frente a la variante ómicron que se identificó en Sudáfrica en noviembre pasado y es la que tiene mayor prevalencia hoy a nivel mundial.
Cómo se hizo el estudio
La efectividad de una vacuna se estima al comparar las tasas de enfermedad en individuos vacunados con las tasas en individuos no vacunados. De esta manera, este estudio arrojó evidencia sobre la efectividad de las vacunas sobre la variante ómicron y delta.
Al cruzar la base de datos de pacientes testeados con los del Sistema Nacional de Gestión de Inmunización (NIMS) –que nuclea los datos de la vacunación en el Reino Unido-, además de datos de registros de salud electrónico y Encuestas de Infección por Covid-19, la UKHSA obtuvo información clave sobre la efectividad de las vacunas. El organismo de salud arribó a la conclusión de que después de dos dosis de la vacuna AstraZeneca, la efectividad de la vacuna contra la variante ómicron comienza en un 45 a 50 por ciento y luego cae casi a casi no tener protección veinte semanas después de la segunda dosis.
Por su parte, con dos dosis de Pfizer o Moderna, la eficacia de las vacunas contra la variante de origen sudafricano se reduce al 65 al 70% tras haber completado el esquema de vacunación, mientras que cae a un 10% a las 25 semanas después de la segunda dosis.
En el estudio se desglosó la información de más tres millones de pacientes contagiados de Covid-19 entre la última semana de diciembre y las tres primeras de enero. La base de datos incluyó todas las franjas etarias: desde menores de 18 años, hasta mayores de 80 años. Así se pudo saber que el mayor número de contagios (683 mil) se dio en los pacientes más chicos, entre los que hubo solo poco más de mil casos detectados en pacientes con esquema de vacunación completo y refuerzo.
Por su parte, los pacientes que siguieron en la lista de contagios en el Reino Unido fueron los de la franja de 18 a 29 años, quienes acumularon unos 603 mil contagios. Mientras que el 18 por ciento no estaba inmunizado, más del 50% de los casos fueron registrados en personas con el esquema de vacunación completo.
En este contexto se observó que quienes recibieron la dosis de refuerzo de la vacuna Pfizer o Moderna, la eficacia contra ómicron para casos sintomáticos oscila entre un 60 y 75%, mientras que cae entre un 25 y un 40% a partir de las 15 semanas o más después del refuerzo. La efectividad de la vacuna es generalmente ligeramente mayor en los grupos de edad más jóvenes en comparación con los de mayor edad, advierte la UKHSA.
Según el estudio británico, la combinación que otorgaría mayor protección para casos sintomáticos sería haber recibido la vacuna Pfizer como esquema de vacunación primario y una dosis de Moderna como refuerzo. Así, luego de quince semanas de su aplicación, la protección rondaría el 60 y el 70%.
En particular el estudio de efectividad de las vacunas contra hospitalizaciones por la variante ómicron ha señalado como clave la implementación del refuerzo para incrementar la protección contra la enfermedad. Dos dosis de las vacunas AstraZeneca (ChAdOx1-S) o Pfizer (BNT162b2) se asociaron con una efectividad de aproximadamente 25 a 35% contra la hospitalización después de la infección con la variante ómicron, después de más de 25 semanas (de haberse aplicado el esquema completo, señalaron desde el organismo sanitario.
Y advirtieron: Después de un refuerzo de Pfizer (luego de cualquier esquema de vacunación primario), la efectividad de la vacuna contra la hospitalización comienza en un 90% y cae en torno al 75 % después de 10 a 14 semanas de su aplicación. Después de un refuerzo de Moderna (ARNm-1273) (después de cualquier ciclo de vacunación primaria), la efectividad de la vacuna contra la hospitalización fue del 90 al 95 % hasta 9 semanas después de la vacunación.
En un análisis sobre distintos escenarios, la información reciente no permite todavía definir qué nivel de protección tienen las vacunas para venir infecciones de la variante ómicron. Para casos sintomáticos, la efectividad en pacientes con dos dosis comienza entre un 70 y 25 por ciento en los primeros tres meses de aplicación y cae a casi 0 por ciento a los seis meses. Una vez aplicado el refuerzo, la efectividad vuelve a subir entre un 75 y un 50 por ciento. Luego de seis meses, todavía no hay información suficiente.
El nivel de efectividad para prevenir la mortalidad ante la variante ómicron se estanca entre un 70 y 40 por ciento seis meses después de haber recibido el esquema completo de vacunación, mientras que aumenta a casi un 100% una vez recibido el refuerzo.
El análisis del informe
Consultado Juan Pablo Jaworski, virólogo e inmunólogo, investigador del Consejo Nacional de Investigaciones Científicas y Técnicas (Conicet), explicó: Los estudios que lleva adelante el UKHSA son referentes a nivel mundial por la calidad y la cantidad de muestras analizadas. Lo que este relevamiento demuestra es la importancia de dar la dosis de refuerzo más allá de con qué vacuna se llevó adelante el esquema inicial de dos dosis.
Ante la pregunta de si era mejor darse un refuerzo con una vacuna de tecnología ARN mensajero como se hizo en el Reino Unido, dijo: Todas las vacunas son buenas. Entre no darse un refuerzo y dárselo con alguna vacuna, siempre es mejor tener el refuerzo. Las que pueden dar mejores resultados son las que no vienen con un vector viral o virus completo, sino las que presenten la proteína S del coronavirus como pueden ser las de ARN mensajero o, por ejemplo, Novavax que se base en proteínas contra el virus y utiliza una tecnología de nanopartículas recombinantes; Sinopharm también está probando ahora una vacuna con esta tecnología similar. El por qué de esto se debe a la inmunofocalización, ya que, al dar solo la proteína S le estás permitiendo a tu respuesta inmunológica que se focalice en el componente del SARS-CoV-2 y no todo lo otro que viene con el vector..
Sobre si se debe esperar cuatro meses para recibir el refuerzo, Jaworski analizó: Lo concreto es que contra ómicron dos dosis no alcanza. No hay evidencia que indique que tiene que ser mejor al mes, a los dos meses, a los tres, los cuatro o los seis. Lo que sucedió es que en los primeros países con alto porcentaje de vacunación como Israel y Estados Unidos, comenzaron a ver que las personas se contagiaban de ómicron transcurridos seis meses de completar el esquema. Ahí comenzaron a investigar si se debía a que la vacuna perdía efectividad o si se debía a que la nueva variante tenía una mayor posibilidad de evadir la respuesta que generar las vacunas. Había una zona gris en el arranque de la ola de ómicron y no pudieron llegar tampoco a una respuesta definitiva ante esas dos opciones porque había indicios que podía deberse a ambas variables.